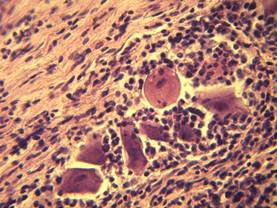

КАТЕГОРИИ:
Архитектура-(3434)Астрономия-(809)Биология-(7483)Биотехнологии-(1457)Военное дело-(14632)Высокие технологии-(1363)География-(913)Геология-(1438)Государство-(451)Демография-(1065)Дом-(47672)Журналистика и СМИ-(912)Изобретательство-(14524)Иностранные языки-(4268)Информатика-(17799)Искусство-(1338)История-(13644)Компьютеры-(11121)Косметика-(55)Кулинария-(373)Культура-(8427)Лингвистика-(374)Литература-(1642)Маркетинг-(23702)Математика-(16968)Машиностроение-(1700)Медицина-(12668)Менеджмент-(24684)Механика-(15423)Науковедение-(506)Образование-(11852)Охрана труда-(3308)Педагогика-(5571)Полиграфия-(1312)Политика-(7869)Право-(5454)Приборостроение-(1369)Программирование-(2801)Производство-(97182)Промышленность-(8706)Психология-(18388)Религия-(3217)Связь-(10668)Сельское хозяйство-(299)Социология-(6455)Спорт-(42831)Строительство-(4793)Торговля-(5050)Транспорт-(2929)Туризм-(1568)Физика-(3942)Философия-(17015)Финансы-(26596)Химия-(22929)Экология-(12095)Экономика-(9961)Электроника-(8441)Электротехника-(4623)Энергетика-(12629)Юриспруденция-(1492)Ядерная техника-(1748)
Бешенство собак
|
|
|
|
Бешенство
БЕШЕНСТВО. ЧУМА ПЛОТОЯДНЫХ. БОЛЕЗНЬ АУЕСКИ. БОЛЕЗНЬ ТЕШЕНА СВИНЕЙ
ЛЕКЦИЯ 8
Бешенство – вирусная инфекционная болезнь млекопитающих, птиц и человека (зооантропоноз). Проявляется признаками энцефалита и тяжелыми нервными расстройствами.
Этиология. РНК-содержащий вирус, рода Lyssavirus, семейства Rhabdoviridas. Вирус в большом количестве содержится в ЦНС, слюнных и слезных железах. Заражение происходит через укусы бешенных животных (слюну), при попадании слюны на поврежденную кожу, слизистые оболочки или рану. Вирус нейротропный. Инкубационный период от 2-х недель до 1 года и более.
Патогенез. Из места внедрения вирус распространяется по периневральным пространствам, достигает головного мозга, накапливается в аммоновых рогах, коре больших полушарий, в мозжечке, продолговатом мозге, вызывает воспаление, дистрофические изменения и некроз нейронов, что проявляется клинически агрессией, параличами глотки, водобоязнью, изменением голоса.
В головном мозгу развиваются следующие изменения: негнойный лимфоцитарный энцефалит, узелки бешенства, тельца Бабеша-Негри.
Заболевание протекает в буйной форме, характеризующейся агрессией, буйством, параличами; в тихой (паралитической); атипичной, проявляющейся истощением, гастроэнтеритами, параличами; абортивной, заканчивающейся выздоровлением.
Патанатомия. При вскрытии трупов соблюдают меры личной безопасности! Специфические морфологические изменения у животных отсутствуют. У собак: истощение, цианоз слизистых оболочек, застойные явления в органах. Сгущение крови. Сухость кожи, подкожной клетчатки, серозных покровов. Эрозии на слизистой оболочке ротовой полости и языка. В желудке несъедобные предметы, застойная гиперемия, кровоизлияния, эрозии. Кишечник – острое катаральное воспаление.
У крупного рогатого скота – переполнение преджелудков сухими кормовыми массами. Сычуг – серозное воспаление, кровоизлияния. Парез мочевого пузыря. Могут быть несъедобные предметы.
Рис. 2.1. – 2.6.
Основные патологоанатомические изменения:
1. Пустой желудок или инородные предметы в нем.
2. Венозная гиперемия, кровоизлияния и эрозии в слизистой оболочке желудка.
3. Сгущение крови (ангидремия), сухость серозных покровов, подкожной клетчатки и кожи.
4. Общий венозный застой: цианоз слизистых оболочек, острая венозная гиперемия печени, легких, селезенки, головного мозга.
5. Гисто: негнойный лимфоцитарный энцефалит в стволовой части головного мозга (четверохолмие, варолиев мост, продолговатый мозг).
- узелки бешенства в стволовой части головного мозга;
- тельца Бабеша-Негри в нервных клетках аммоновых рогов.
Диагноз: учитывают клинико-эпизоотические особенности, результаты вскрытия. Гистологически в продолговатом мозге, четверохолмии, аммоновых рогах и мозжечке обнаруживают негнойный лимфоцитарный энцефалит, а в продолговатом мозге, четверохолмии, узловатом ганглии блуждающего нерва, в межпозвоночных ганглиях – узелки бешенства. Важное гистологическое значение имеет обнаружение в цитоплазме нейронов аммоновых рогов включений – телец Бабеша-Негри. Проводят также иммунолюминесцентную микроскопию и биопробу на лабораторных животных.
Дифференцировать нужно от чумы собак, болезни Ауески, листериоза, ЗКГ крупного рогатого скота, ИЭМ лошадей.

Рис. 4.8.1 Бешенство собак. Кровоизлияния в слизистую оболочку желудка
Стенка желудка не утолщена, упругой консистенции, слизистая оболочка серого цвета, с желтоватым оттенком, хорошо выражена складчатость. По верхушкам складок видны пятнистые кровоизлияния темно-коричневого цвета, с резко очерченными краями. Большинство кровоизлияний бледно окрашено, синеватого цвета, без резких границ переходит в окружающую ткань.

Рис. 4.8.2 Ганглионит при бешенстве
Симпатический ганглий с диффузной воспалительной инфильтрацией.
а)

б)
Рис. 4.8.3 Узелки бешенства в узловатом ганглии блуждающего нерва (а, б)
Строма нервной ткани инфильтрирована лимфоцитами и гистиоцитами. Нервные клетки сморщены или набухшие, местами обесцвечены, расположены в капсуле. Имеются разные стадии формирования узелков бешенства: начало размножения клеток-сателлитов и полное замещение нервных клеток сателлитами в полости капсулы.

Рис. 4.8.4 Тельца Бабеша-Негри красного цвета в нейронах аммонова рога собаки

а)

б)

в)

г)
Рис. 4.8.5 Специфическое свечение вирусинфицированных нейронов при бешенстве: а – корова, б – лиса, в – собака, г – человек
Чума плотоядных
Чума плотоядных – контагиозная вирусная болезнь, характеризующаяся катарально-гнойным воспалением слизистых оболочек носовой полости, глаз, желудочно-кишечного тракта, пневмонией, кожной экзантемой и поражением нервной системы.
Этиология. РНК-содержащий вирус рода Morbillivirus семейства Paramyxoviridae. Болеют собаки, лисицы, еноты, песцы и др., особенно их молодняк в возрасте до 1 года (собаки), до 5 месяцев (пушные звери). Заражение происходит алиментарно и аэрогенно.
Патогенез. Вирус проникает в эпителиальные клетки слизистых оболочек и в регионарные лимфатические узлы, размножается в них, а затем с током крови и лимфы разносится по всему организму и вызывает поражение респираторного и желудочно-кишечного трактов, а также головного мозга и кожи. У собак повышается температура, появляется депрессия, пугливость. Животные кашляют, чихают, наблюдаются серозно-слизисто-гнойные истечения из носа и глаз. Характерно сверхострое и острое течение. Различают легочную, кишечную, нервную, абортивную и смешанную формы болезни.
Патанатомия. Глаза – серозно-гнойный конъюнктивит и кератит. Носовая полость – катарально-гнойный ринит. Легкие – катарально-гнойная пневмония. Кожа – везикулярный или пустулезный дерматит. Желудок, кишечник – острое катаральное воспаление, эрозии, язвы. Печень, почки, миокард – зернистая или жировая дистрофия. Гисто: негнойный лимфоцитарный энцефалит.
Рис. 3.1. -3.2.
Основные патологоанатомические изменения:
1. Катарально-гнойный ринит, конъюнктивит и кератит (гнойный панофтальмит).
2. Катарально-гнойная бронхопневмония.
3. Серозное воспаление бронхиальных, брыжеечных и других лимфоузлов.
4. Катарально-язвенный гастроэнтерит.
5. Зернистая и жировая дистрофия печени, почек, миокарда.
6. Инфекционная сыпь на коже (папулы, пустулы, корочки).
7. Гисто – негнойный лимфоцитарный энцефалит.
Диагноз: учитывают клинико-эпизоотологические особенности, результаты вскрытия и гистологического исследования головного мозга.
Дифференцировать нужно от бешенства, болезни Ауески, лептоспироза, кишечных гельминтозов.

Рис. 4.8.6 Чума собак
Инфаркты селезенки с наложениями фибрина на капсуле.
|
|
|
|
|
Дата добавления: 2014-01-20; Просмотров: 1989; Нарушение авторских прав?; Мы поможем в написании вашей работы!